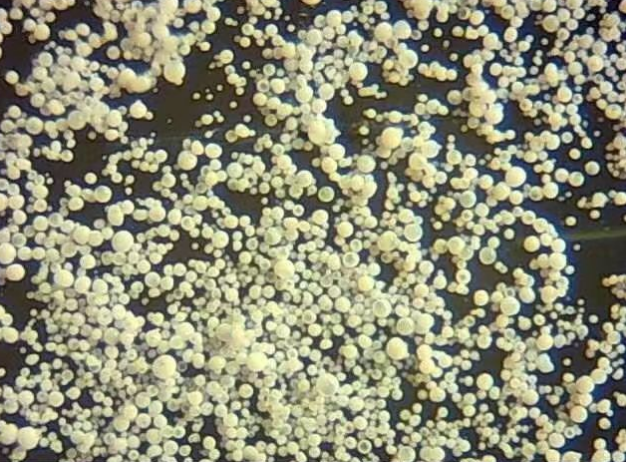

2023年8月7日,工業(yè)和信息化部發(fā)布了《石化化工行業(yè)鼓勵推廣應用的技術和產(chǎn)品目錄(第二批)》,《目錄》包含28項技術/產(chǎn)品,由鄭州大學化學學院教授王向宇率領團隊研發(fā)的高性能微球鈦硅分子篩催化劑,位列其中。
分子篩課題組的實驗室不大,井井有條地擺放著一排排的瓶瓶罐罐和各種儀器,很難想象,能夠生產(chǎn)數(shù)千噸、助企贏利數(shù)十億的產(chǎn)品,是在這個三四十平方米的房間中研發(fā)出來的。尋常的外表下,該實驗室卻藏著很深的“高科技”。
自主創(chuàng)新攻克“分子篩”卡脖子難題
分子篩是一種多孔材料,顧名思義,它可以對分子進行篩選,將不同大小和形狀的分子進行識別和分離,具有非常強的分離、吸附和催化功能?!按騻€比方,分子篩像一個蜂巢。在其內(nèi)部設計有針對性功能的空間和通道,反應分子進入分子篩孔內(nèi)被激活、剪裁、組合、加工等,進而加快反應速度和提高產(chǎn)物收率。”王向宇說。
國際上公認的鈦硅分子篩法生產(chǎn)技術被發(fā)達國家長期壟斷,技術不轉讓,產(chǎn)品價格昂貴。即便如此,國外的催化劑仍存在一些問題,催化劑生產(chǎn)技術“門檻高”、工藝復雜,存在活性低、分離難、較多廢液等難點。
十多年前,學院組織教師去企業(yè)考察。在一家企業(yè)中,王向宇發(fā)現(xiàn)該企業(yè)花了幾十億元購買國外成套生產(chǎn)線設備,但其中的核心技術——催化劑生產(chǎn)技術被壟斷,企業(yè)需要持續(xù)購買國外價格昂貴的催化劑,限制了企業(yè)發(fā)展?!拔疑钍苡|動,我們必須自主研發(fā),打破國外技術壟斷,努力攻關分子篩生產(chǎn)技術研發(fā),實現(xiàn)自主創(chuàng)新?!蓖跸蛴钫f。
于是,團隊自2004年開始研發(fā),歷時16年,攻克了這項技術。“和學校一般作息不同,我們團隊每周上六天班。”采訪中,王向宇不經(jīng)意的一句話流露出該團隊的工作常態(tài)。

團隊深扎功夫在實驗室,數(shù)千次甚至萬次以上長時間的實驗驗證,最終,他們做出系列創(chuàng)新,研發(fā)的“微球型鈦硅分子篩”有諸多優(yōu)點:原料豐富,成本低。原材料主要是硅,而硅是地球表面第二豐富的元素,僅次于氧,能降低成本82%;活性高,轉化效率高,能達到99.99%的行業(yè)最高指標;耐腐性強,易捕捉、節(jié)能……
由中國科學院院士于吉紅、韓布興,中國工程院院士劉中民等組成的專家組經(jīng)過考察后,給予高度評價。
深入應用“比拿多少錢、多少獎都高興”
“無論項目大小,能夠轉化應用,對團隊都是莫大的鼓勵和慰藉,這種喜悅比拿多少錢、多少獎都高興。”王向宇說。
30年前,王向宇就開始了校企合作工作?!叭ブ?,很榮幸,也有一定壓力。我們作為博士、教授,去企業(yè)能否給人家?guī)椭?,能否為他們解決一些實質問題,也是有一些顧慮的?!蓖跸蛴畋硎?。通過不斷和企業(yè)接觸,王向宇帶領團隊在解決各種問題中研發(fā)攻關,實現(xiàn)了大大小小的科研成果轉化應用,使團隊能快速為企業(yè)把脈問診,找到問題癥結,很多企業(yè)慕名來談合作。
近10年來,該分子篩技術的工業(yè)應用不斷擴大。技術廣泛應用于尼龍基本原料的清潔生產(chǎn),“主要應用于尼龍6,尼龍6的全球市場約每年800-1000萬噸,常見用途是工程塑料和錦綸服裝?!蓖跸蛴钫f。
目前,由團隊研發(fā)的環(huán)己酮氨肟化專用鈦硅分子篩催化劑,已成功應用于中國平煤神馬集團、魯西集團、山東東巨化工股份有限公司等多家企業(yè)的己內(nèi)酰胺生產(chǎn)裝置。
“近幾年,應用該技術催化劑的己內(nèi)酰胺生產(chǎn)裝置年產(chǎn)能為120萬噸,國內(nèi)市場占有率達到1/3,為企業(yè)合計新增效益64億元、新增利潤超過10億元?!蓖跸蛴罱榻B。
“雙向奔赴的努力,大家都會很開心”
“企業(yè),要效益要利益。我們作為大學教師,要有知識要有能力,要為社會做一些貢獻。這樣雙向奔赴的努力,大家都會很開心?!钡谝淮螛s獲科技進步獎時,王向宇對企業(yè)說了這樣一句話。
“我們公司與王向宇教授的合作從2015年開始?!焙颖蹦成鲜泄靖笨倓⒊G嗵峒巴跸蛴钯澴u有加。校企合作后,公司有了自己的“技術+設備+催化劑”系列產(chǎn)品,在催化劑方面的技術能力、創(chuàng)新能力明顯提升。為了加快推進合作項目的進展,王向宇經(jīng)常犧牲休息時間,為公司有關技術人員進行培訓、答疑、解惑。公司不僅提高了一次性的銷售收入,還依靠催化劑形成穩(wěn)定的連續(xù)收入,提升了公司在行業(yè)中的聲譽和地位,并促使公司參加國家組織《環(huán)氧丙烷能耗限額標準》制定,為行業(yè)進步作出貢獻。
2021年3月初,一個項目的中試放大實驗急需在外地合作工廠進行。當時由于疫情,那個城市全市只開一個賓館,離工廠比較遠,食宿很不便。王向宇每天開車帶團隊早出晚歸,堅持工作在工廠一線。
“王老師每天都在車間忙碌,和工人一樣,一身汗一身塵,就這樣我們在工廠呆了一個月,在疫情中搶時間,順利完成了中試放大實驗?!睂W生楊許可提及那段日子依然記憶猶新。
中國平煤神馬能源化工集團有限責任公司、魯西催化劑有限公司、河北美邦工程科技股份有限公司……王向宇帶領團隊走過的足跡,遍布河南、河北、山東、山西、江蘇等多個省份,數(shù)十個企業(yè)都與之有技術合作開發(fā)和技術應用的服務。
對于多年的校企合作經(jīng)驗,王向宇寫下了這樣的深刻思考:“科技人員就應大膽走出去,到企業(yè)第一線去,為企業(yè)把脈定向,解決難題,在實踐中研究和創(chuàng)新,真切地體會到學生培養(yǎng)、科學研究的方向性和社會價值感。”
聲明:化學加刊發(fā)或者轉載此文只是出于傳遞、分享更多信息之目的,并不意味認同其觀點或證實其描述。若有來源標注錯誤或侵犯了您的合法權益,請作者持權屬證明與本網(wǎng)聯(lián)系,我們將及時更正、刪除,謝謝。 電話:18676881059,郵箱:gongjian@huaxuejia.cn